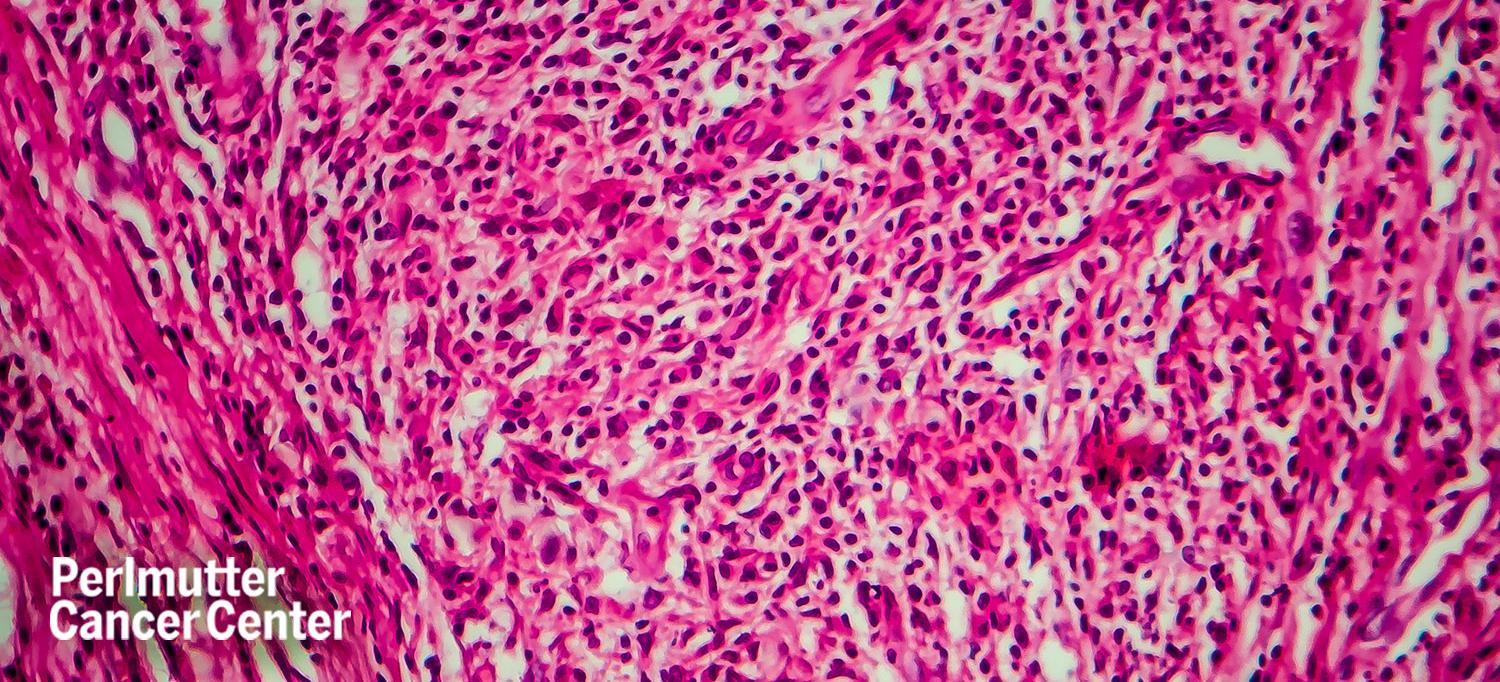

Photo: Dr_Microbe/Getty
Country singer Ashley Monroe recently announced she was being treated for a rare blood cancer called Waldenstrom macroglobulinemia, a type of non-Hodgkin lymphoma.
A common first sign of Waldenstrom macroglobulinemia is swollen lymph nodes, but up to 25 percent of patients do not experience any symptoms at the time of their diagnosis, Catherine S. Diefenbach, MD, associate professor in the Department of Medicine and director of the Clinical Lymphoma Program at NYU Langone Health's Perlmutter Cancer Center, tells Health.
“For patients who are asymptomatic and do not have significant laboratory abnormalities, there is no data showing that treating a patient when they are well and without symptoms will improve survival,” Dr. Diefenbach says. “Thus treatment is limited to patients who are symptomatic, have a significant disease burden, or significant laboratory abnormalities.”
Read more from Health.

